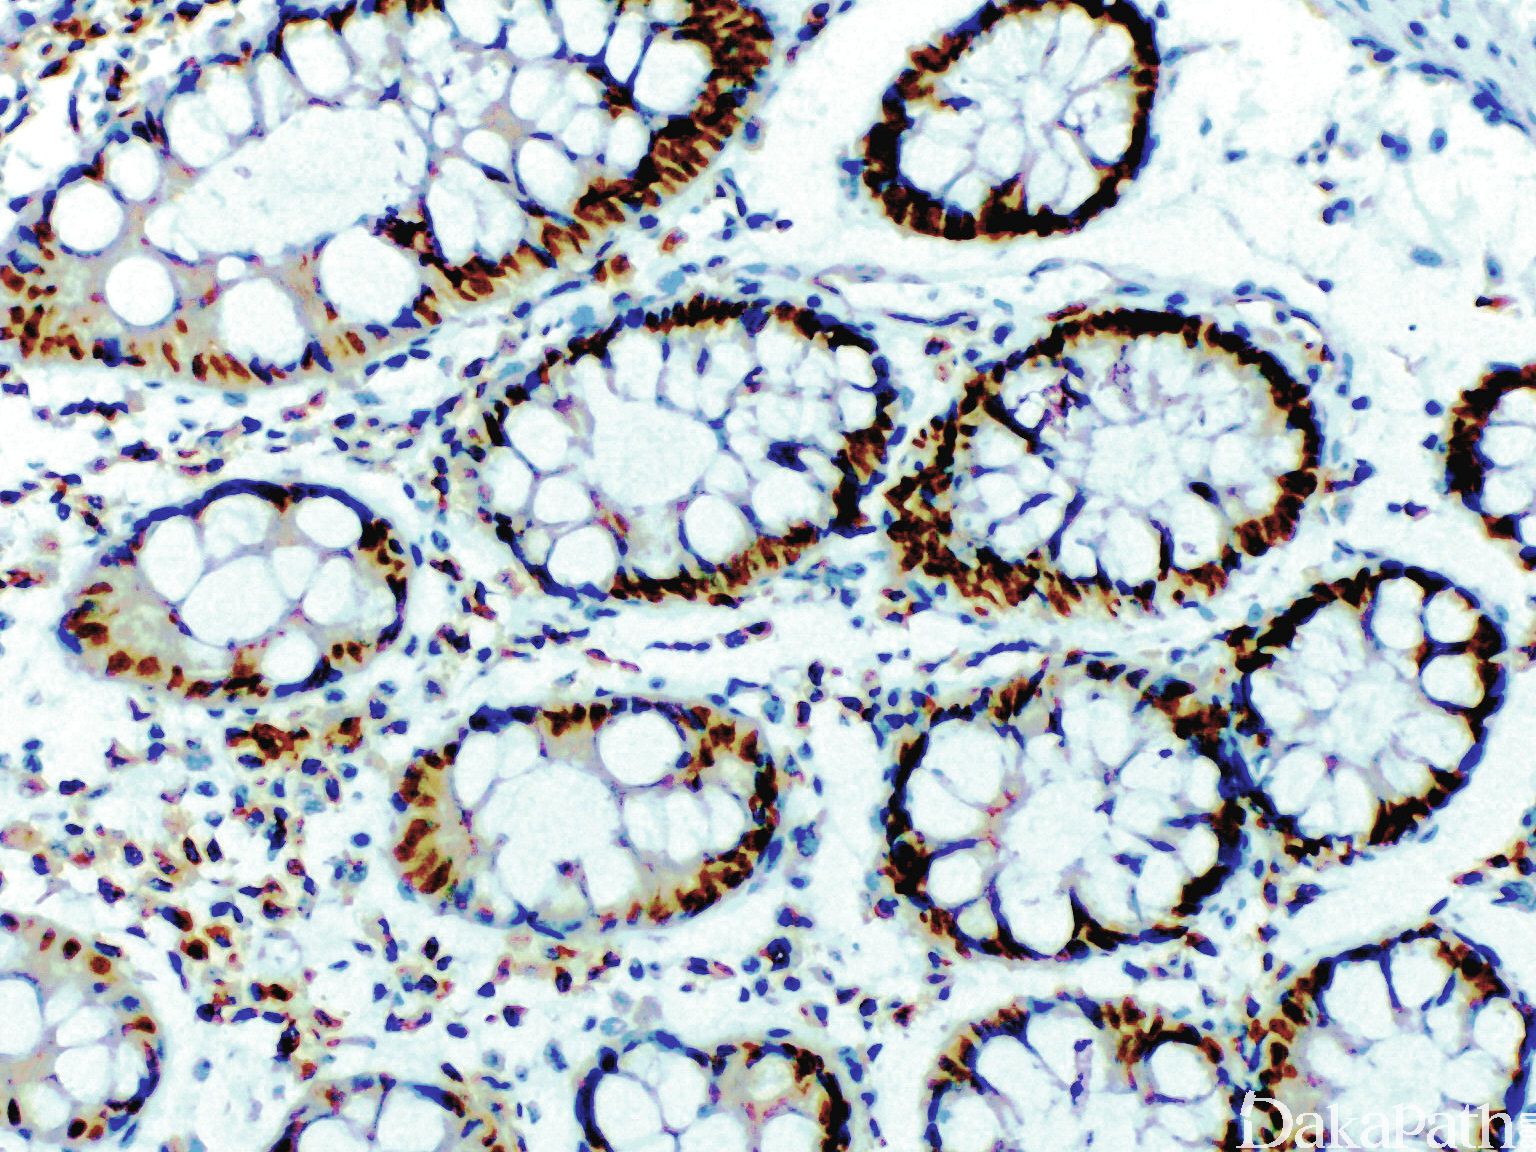
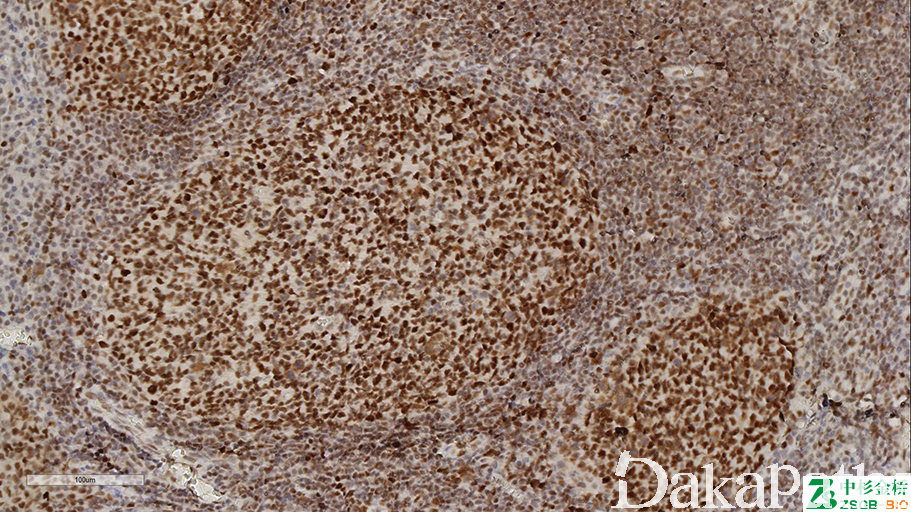

PMS2

概述:
为错配修复基因,正常结肠黏膜细胞核阳性,突变后表达丢失
信号定位: 胞核
在病理学中的应用:
联合检测 MLH1, MSH2, PMS2 和 MSH6 可用于 Lynch syndrome(遗传性非息肉性结肠癌)的筛查
商品化试剂(排名不分先后,本网站对抗体质量不负责!)
公司 | 克隆号 | 即用型(ml) | 原液(ml) | ||||
基因科技 | EP51 | / | 2 | 4 | 7 | / | 0.2 |
中杉金桥 | M0R4G | 1.5 | 3 | 6 | / | 0.1 | 0.2 |
EP51 | |||||||
安必平 | EP51 | 1.5 | 3 | 6 | / | 0.1 | 0.2 |
福建迈新 | M0R4G | 1.5 | 3 | 6 | / | / | 0.2 |
在肿瘤中的表达情况:
几乎全部阳性(≥95%的病例阳性): 皮脂腺腺癌、皮脂腺腺瘤、壶腹腺癌,肠型、透明细胞肾细胞癌、皮脂腺上皮瘤、子宫内膜透明细胞癌、壶腹腺癌,胰胆管型、壶腹癌
通常阳性(<95%,≥75%的病例阳性): 结直肠腺癌、子宫内膜腺癌、小肠腺癌、子宫内膜浆液性癌、结直肠腺癌,家族息肉病相关、胰腺导管腺癌
少数阳性(<35%,≥15%的病例阳性): 结直肠淋巴上皮瘤样癌
几乎全部阴性(<5%的病例阳性): 食管未分化癌
